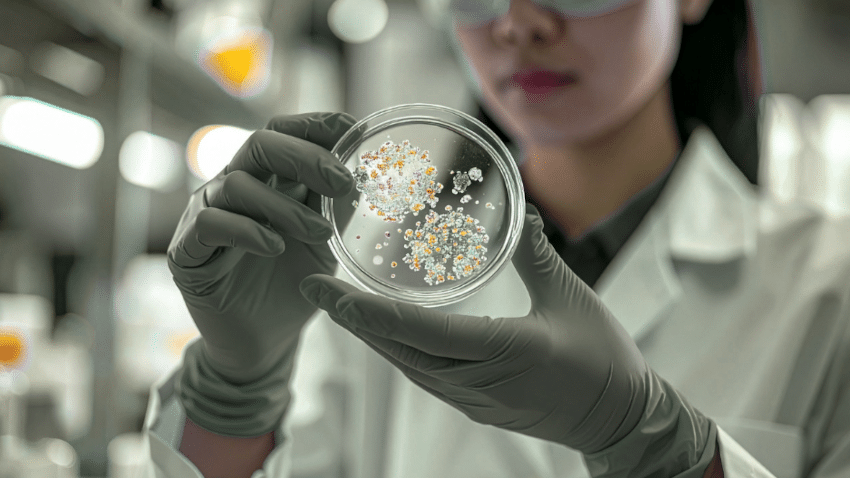
Forschung aus Hof | Ein Team denkt Textilbeschichtung neu

Warum nachhaltige Mode oft am falschen Punkt ansetzt
Wenn von nachhaltiger Mode die Rede ist, stehen meist Materialien wie Bio-Baumwolle oder Recyclingfasern im Fokus. Deutlich weniger Aufmerksamkeit bekommt ein Bereich, der für die Umweltbilanz mindestens genauso entscheidend ist: die Veredelung von Textilien.
Denn Drucke, Beschichtungen und funktionale Ausrüstungen basieren in vielen Fällen noch immer auf fossilen Polymeren. Gerade bei kurzlebigen Produkten aus dem Fast-Fashion-Segment entsteht so ein strukturelles Problem: Die Nutzungsdauer ist sehr kurz, die eingesetzten Materialien bleiben jedoch sehr lange in der Umwelt.
Genau hier setzt ein Forschungsprojekt an, das einen bislang wenig genutzten Rohstoff in den Mittelpunkt stellt: Pilzreste.
Inhaltsverzeichnis
Forschung aus Hof | Ein Team denkt Textilbeschichtung neu
Am Campus Münchberg der Hochschule Hof arbeitet ein interdisziplinäres Team daran, fossile Beschichtungen durch biobasierte Alternativen zu ersetzen. Beteiligt sind unter anderem die Forschungsgruppenleiterin Alexandra Luft sowie die Wissenschaftlerin Dr. Katharina Wellmanns. Gemeinsam mit dem Industriepartner Willy Maisel GmbH wird die Technologie nicht nur entwickelt, sondern direkt unter realen Produktionsbedingungen getestet.
Das Projekt „DisAPPrint“ läuft von 2026 bis 2027 und verbindet Materialwissenschaft, Chemie und Textiltechnik in einem gemeinsamen Ansatz. Ziel ist es, Innovation nicht im Labor enden zu lassen, sondern unmittelbar in die industrielle Anwendung zu bringen.
Die Idee | Aus Abfall entsteht neuer Nutzen
Im Zentrum steht ein Material, das in Europa in großen Mengen anfällt und bisher kaum genutzt wird: Reststoffe aus der Pilzproduktion.
Diese werden im Projekt zu Chitosan verarbeitet, einem biobasierten Polymer, das sich in Lösung in eine gelartige Masse verwandelt. Auf Textilien aufgetragen, bildet es einen dünnen Film, der klassische Beschichtungen ersetzen kann.
Was dabei entsteht, ist mehr als ein neuer Werkstoff. Es ist ein anderer Ansatz von Wertschöpfung: Bestehende Ressourcen werden genutzt, anstatt neue zu erschließen.
Infografik | Vom Pilz zur nachhaltigen Textilbeschichtung
🍄PILZPRODUKTION
/ Lebensmittelindustrie
▼
♻️ RESTSTOFFE
/ ungenutzte Biomasse
▼
🧪 CHITOSAN
/ biobasiertes Polymer
▼
🧴 BESCHICHTUNG
/ gelartige Filmstruktur
▼
👕 TEXTILDRUCK
/ Sieb- oder Digitaldruck
▼
🌱 NACHHALTIGE OBERFLÄCHE
/ ohne fossile Polymere
Entscheidend ist der Alltag, nicht das Labor
Die eigentliche Stärke des Projekts liegt darin, dass es konsequent von der Anwendung her gedacht wird. Eine Beschichtung muss nicht nur technisch funktionieren, sondern im regelmäßigen Gebrauch bestehen.
Ein bedrucktes Kleidungsstück wird getragen, kommt mit Schweiß in Kontakt, wird möglicherweise mit Getränken verschüttet und anschließend gewaschen. Genau diese Nutzungskette wird gezielt simuliert. Gleichzeitig prüfen die Forschenden, wie sich das Material auf unterschiedlichen Textilien wie Baumwolle und Polyester verhält und ob es sich problemlos in bestehende Druckprozesse integrieren lässt.
Erst wenn all diese Bedingungen erfüllt sind, wird aus einer Materialidee eine industrielle Lösung.
Der größere Trend | Pilze als neue Materialbasis
Die Entwicklung steht exemplarisch für einen breiteren Wandel. Pilze und ihre Strukturen – insbesondere Myzel – werden zunehmend als vielseitige Materialplattform erforscht.
Ob als vegane Lederalternative, Verpackungsmaterial oder Baustoff – der Grundgedanke bleibt gleich: Materialien wachsen nach, benötigen vergleichsweise wenige Ressourcen und lassen sich gezielt funktionalisieren.
Damit verschiebt sich die Logik von industrieller Produktion hin zu biologisch inspirierten Prozessen bzw. Kreisläufen.
Warum Chitosan ein Schlüsselmaterial werden könnte
Chitosan ist kein völlig neuer Stoff, aber seine Rolle in der Textilindustrie entwickelt sich gerade erst. Das Biopolymer besitzt Eigenschaften, die es besonders interessant für Beschichtungen machen.
Es ist biologisch abbaubar, kann stabile Filme bilden und weist natürliche antimikrobielle Eigenschaften auf. Gleichzeitig lässt es sich so verarbeiten, dass bestehende Produktionsprozesse nicht grundlegend verändert werden müssen.
Bereits heute wird Chitosan in anderen Bereichen eingesetzt, etwa in der Medizin oder Verpackungsindustrie. Auch in der Textilforschung zeigt sich, dass es fossile Chemikalien wie PFAS perspektivisch ersetzen kann.
Die größte Herausforderung | Nachhaltigkeit reicht nicht aus
So vielversprechend der Ansatz ist, der entscheidende Maßstab bleibt die Praxis. Eine Beschichtung muss nicht nur ökologisch sinnvoll sein, sondern auch funktional überzeugen.
✅ gleichbleibende Materialqualität trotz biologischer Rohstoffe
✅ Haltbarkeit und Waschbeständigkeit
✅ angenehme Haptik und Tragekomfort
✅ Integration in industrielle Abläufe
Die zentrale Herausforderung besteht darin, diese Anforderungen mit nachhaltigen Materialien in Einklang zu bringen.
Warum genau hier der größte Hebel liegt
Viele nachhaltige Innovationen konzentrieren sich auf das sichtbare Produkt – etwa die Faser oder das Design. Beschichtungen bleiben dagegen meist unsichtbar, sind aber entscheidend für Funktion und Umweltwirkung.
Gerade weil sie selten im Fokus stehen, bieten sie enormes Potenzial. Wird dieser Bereich nachhaltig transformiert, kann das große Teile der Textilproduktion betreffen, ohne dass sich das Produkt für den Endkunden grundlegend verändert.
Fazit | Eine unsichtbare Innovation mit realem Impact
Pilzbasierte Textilbeschichtungen zeigen, wie tiefgreifend nachhaltige Innovation sein kann, wenn sie an den richtigen Stellen ansetzt.
Nicht das Material allein entscheidet über Nachhaltigkeit, sondern das Zusammenspiel aus Rohstoff, Verarbeitung und Nutzung. Projekte wie „DisAPPrint“ machen deutlich, dass sich genau hier neue Wege eröffnen – technisch, wirtschaftlich und ökologisch zugleich.
Wenn sich solche Ansätze durchsetzen, könnten sie einen bislang unterschätzten Bereich der Mode grundlegend verändern.
Mehr Infos + Artikel zu nachhaltiger Mode
- Was ändert sich in der Modeindustrie durch den Digitalen Produktpass (DPP)?
- Vegane Kinder-Regenjacken und -Matschhosen ohne PFAS kaufen
- Neuer Expertenrat für nachhaltige Mode gegründet
- Amazon und Nachhaltigkeit – 6 empfehlenswerte Marken für Bio-Damen-Basickleidung bei Amazon
- Ressourcenschonend durch die Monatsblutung kommen – schöne XXL-Periodenunterwäsche im Vergleich